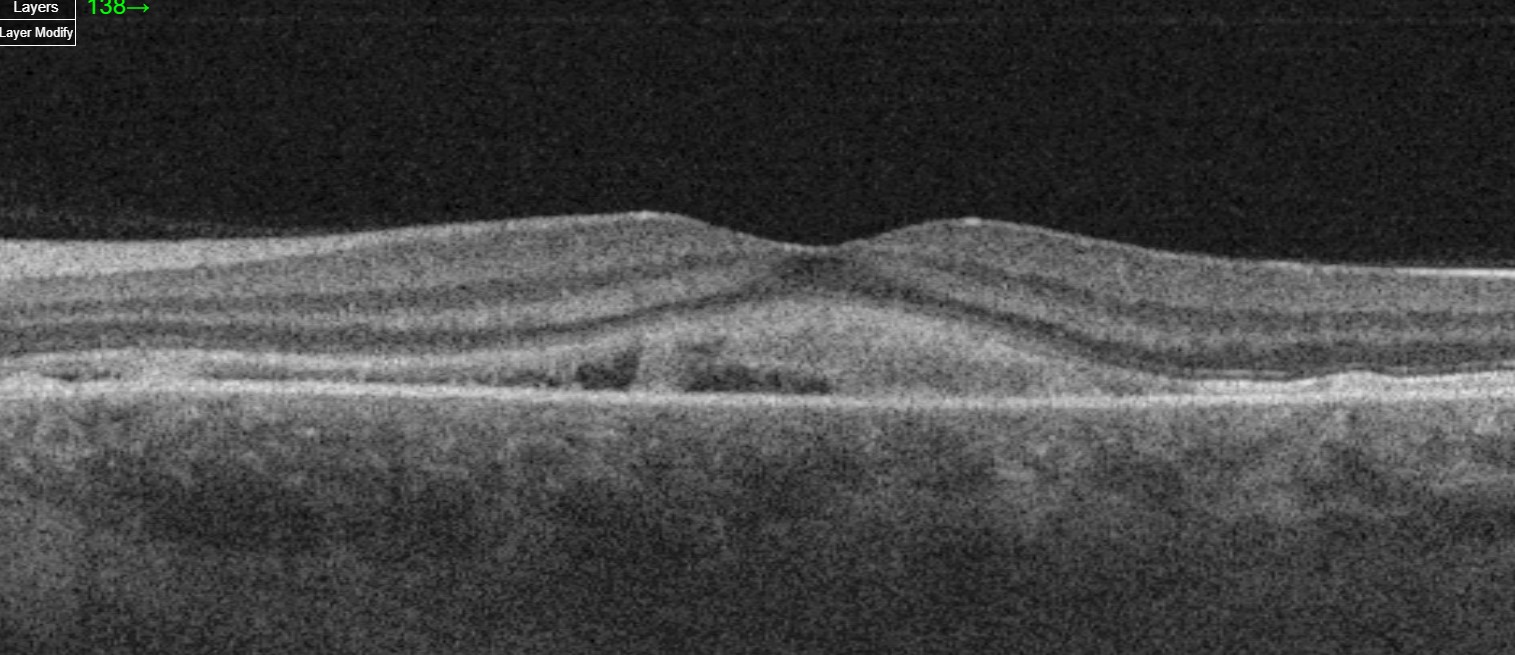
Bilateral serous retinal detachment with associated subretinal fibrin-like material in a case of pregnancy-induced hypertension.

Preeclampsia/Eclampsia Associated Retinopathy
All content on Eyewiki is protected by copyright law and the Terms of Service. This content may not be reproduced, copied, or put into any artificial intelligence program, including large language and generative AI models, without permission from the Academy.
Hypertensive disorders are seen in 10% of all pregnancies and include gestational hypertension, preeclampsia, eclampsia, and HELLP (Hemolysis, Elevated liver enzymes, Low Platelet count) syndrome. HELPP syndrome is considered a severe form of preeclampsia that usually occurs in the 3rd trimester or shortly after childbirth, and can present with concurrent retinal involvement. Serous retinal detachment can be found in 1-2% of the cases with preeclampsia/eclampsia.
Disease Entity
Preeclampsia/eclampsia associated retinopathy refers to the retinal pathologies seen in the hypertensive disorders of pregnancy.
Preeclampsia is defined as new-onset hypertension after 20 weeks of gestation and proteinuria and/or evidence of end-organ compromise, including CNS symptoms (headache and/or visual changes), pulmonary edema, thrombocytopenia, renal insufficiency, or liver dysfunction.[1]
HELLP syndrome is on the severe spectrum of preeclampsia with severe systemic signs and is not specifically characterized as a separate entity by the American College of Obstetrics and Gynecologists (ACOG).[1]
Eclampsia is diagnosed with new-onset of generalized seizures in a woman with preeclampsia.[1]
Disease
Preeclampsia/eclampsia associated retinopathy is characterized by retinal arteriolar narrowing due to systemic hypertension and ischemia that may cause damage to the retinal and choroidal vasculature and to the retinal pigmented epithelium (RPE).
This ischemic state may commonly manifest as 1) reduced arteriolar caliber and arteriovenous ratio, 2) retinal hemorrhages, 3) edema, 4) cotton wool spots secondary to arteriolar damage, 5) choroidal dysfunction with secondary RPE damage, 6) serous retinal detachment, 7) retinal pigment epitheliopathy, 8) vitreous hemorrhage.[2][3]
Other potential findings include 1) peripheral retinal neovascularization, 2) choroidal neovascularization, 3) macular edema, 4) macular ischemia, 5) tear of the retinal pigment epithelium, 6) bilateral Purtscher’s like- retinopathy, 7) retinal arterial and venous occlusion, and 8) disseminated intravascular coagulopathy (DIC).[3][4]
Etiology
Exudative RD can be seen in 0.2–2% of patients with severe pre-eclampsia and 0.9% with HELLP syndrome.[5] Various theories exist regarding the pathogenesis of ERD in eclampsia. An increase in endogenous vasoconstrictor agents occur in pre-eclampsia and eclampsia can cause vasoconstriction and fibrinoid necrosis of choroidal vessels. Injury to chori�ocapillaris by ischemia or thrombosis due to disseminated intravascular coagulation has also been reported. [6][7]
Epidemiology
The visual system may be affected in 30–100% of patients with pre-eclampsia. The most common ocular finding is severe arteriolar spasm, evidenced by either segmental or generalized constriction of the retinal arterioles reported in 70% of cases of toxemia. 1–2% of patients who develop severe hypertension, proteinuria, and edema during the third trimester of pregnancy develop loss of vision as a result of serous retinal detachment. Retinal pigment epithelium damage and Purtscher's like retinopathy have been reported.[2][3][4]
Risk Factors
In a report published by Lupton et al, normotensive pregnant women were followed with retinal vessel analysis and blood pressure measurements throughout gestation; he found that those who later developed preeclampsia had significant vessel attenuation early in gestation. [8] In pregnant women every 10-mmHg increase in mean arterial blood pressure was associated with a 1.9-μm reduction in retinal arteriolar caliber.
Risk factors for preeclampsia include primiparity, age 40 years or greater, chronic hypertension, obesity, renal disease, pregestational diabetes, lupus, thrombophilia, antiphospholipid syndrome, multifetal gestation, in vitro fertilization, history of preeclampsia in prior pregnancy, or family history of preeclampsia. Most cases arise in the late preterm and term periods.
General Pathology
Preeclampsia is a systemic syndrome of pregnancy originating in the placenta. It is thought to be caused by inadequate placental cytotrophoblast invasion, followed by widespread maternal endothelial dysfunction.
Research has demonstrated that excess quantities of the antiangiogenic factors soluble fms-like tyrosine kinase-1 (sFlt1) and soluble endoglin (sEng) are released by the placenta into maternal blood, causing widespread endothelial dysfunction that results in hypertension, proteinuria, and other systemic manifestations of preeclampsia.
The two important antiangiogenic factors implicated in preeclampsia are soluble vascular endothelial growth factor (VEGF) and soluble endoglin. Nitric oxide signaling is involved in vascular relaxation and is reduced in preeclampsia. The molecular basis for placental dysregulation of these pathogenic factors remains unknown.
Diagnosis
The diagnosis is made based on fundoscopy findings and patient history during pregnancy including a review of blood pressure levels along with kidney and liver function test levels.
History
Preeclampsia/eclampsia visual disturbances were first described by Soranus from Ephesus (approx. 120 A.D.); later in 1855, A. von Graefe (1855) first observed serous retinal detachment in patient with this pregnancy hypertensive disorder.
Signs
The commonest ocular finding is severe arteriolar spasm, evidenced by either segmental or generalized constriction of the retinal arterioles reported in 70% of cases of preeclampsia/eclampsia and HELLP syndrome.
Serous retinal detachment usually occurs before or after delivery, the detachment may be confined to the macula or may involve the entire fundus (serous retinal detachment are more common in patients presenting eclampsia) and may rarely be associated with bleeding into the choroid, subretinal space, and vitreous.
A branching pattern of yellow-white patches caused by focal necrosis of the RPE and outer retina may or may not be evident.
These patients may or may not show evidence of cotton-wool patches and hemorrhages in the retina. After delivery and treatment of the hypertension, the detachment rapidly resolves and recovery of visual function is relatively complete in most patients.
An irregular branching pattern of hyperpigmented dots (Elschnig spots), yellowish patches, and interconnecting lines of depigmentation of the RPE often remains in the juxtapapillary and macular area . These changes, caused by infarction of the RPE, are frequently symmetric in both eyes and, if initially detected on a routine eye examination years later, may be incorrectly interpreted as signs of a macular dystrophy.
Symptoms
- Blurred vision, is the most common symptom.
- Color vision disturbances
- Decreased visual field
Clinical Diagnosis
Diagnosis is based on a combination of fundoscopic findings and the patient’s history, particularly if there is a history of pregnancy-related complications such as preeclampsia, eclampsia, or HELLP syndrome. These conditions are associated with systemic hypertension, which can lead to a variety of retinal and choroidal changes. Ancillary tests are crucial for confirming the diagnosis and evaluating the extent of ocular involvement.[9]
- Fundoscopy and OCT Findings:
- Macular Subretinal Fluid: Fundoscopy and OCT imaging often reveal significant subretinal fluid accumulation under the macula, impairing vision. This fluid results from leakage due to damaged blood vessels in the retina or choroid.
- Subretinal Deposits or Fibrin: OCT can detect subretinal deposits or fibrin, indicating severe inflammation or exudation caused by the breakdown of the blood-retina barrier. These changes usually resolve rapidly as systemic hypertension improves, though they signify substantial vascular compromise.
- RPE Mottling: Irregular pigmentation or mottling of the retinal pigment epithelium (RPE) may persist even after the acute fluid and deposits have resolved, reflecting chronic damage to the RPE cells.
- Retinal Hemorrhages: Fundoscopy may also reveal retinal hemorrhages, including flame-shaped hemorrhages, dot-blot hemorrhages, or in severe cases, preretinal or subretinal hemorrhages. These indicate significant retinal vascular damage.
- Papilledema: In some cases, there may be swelling of the optic disc (papilledema), particularly if the systemic hypertension is severe or associated with increased intracranial pressure. Papilledema is a serious finding, indicating that the optic nerve and potentially the brain are also affected.
- Ancillary Tests:
- Fluorescein Angiography (FA): This imaging technique can show delayed perfusion in segments of the choroid and multiple pinpoint areas of dye leakage through the RPE, particularly around subretinal yellow-white patches. Early in the disease course, FA may reveal delayed choriocapillaris perfusion due to ischemia, while later stages exhibit a multifocal reticular staining pattern over areas of RPE damage.
- Fundus Autofluorescence (FAF): FAF helps assess RPE integrity and detect areas of hyper- or hypofluorescence, correlating with regions of RPE damage or subretinal deposits.
- Ultrasonography (B-Scan): B-mode ultrasound is useful for documenting and monitoring serous retinal detachment, which can occur in hypertensive retinopathy. It provides valuable insights into the extent and progression of retinal detachment.
- Ultrasonography
- Visual Fields
Differential diagnosis
- Central Serous Chorioretinopathy
- Vogt-Koyanagi-Harada (VKH) disease
- Disseminated intravascular coagulopathy (DIC)
- Pattern Dystrophy
Management
Medical therapy
Usually no treatment is needed for serous retinal detachments besides prompt delivery of the baby and placenta especially in HELPP syndrome ; however, steroids and anti hypertensive drugs have been reported in the treatment of this entity. The exudative retinopathy resolves as the underlying eclampsia is treated.
Complications
Patients with severe toxemia may develop profound visual loss and blindness secondary to total serous and hemorrhagic retinal detachment and be left following recovery with extensive degenerative changes in the RPE and retina that may simulate a diffuse tapetoretinal dystrophy. Correct diagnosis is important since the changes caused by toxemia are nonprogressive.
Cases with severe preeclampsia may be left with permanent visual loss, despite resolution of the serous retinal detachment due to extensive RPE necrosis.
Prognosis
Most patients with retinal detachment in pregnancy induced hypertension have full spontaneous resolution within a few weeks, and do not have any sequelae. The vision improves rapidly as the systemic hypertension and underlying renal function improves. Subretinal white linear deposits may be seen as the serous retinal detachment resolves and these may take months to completely disappear.
Additional Resources
For information about other ocular alterations during pregnancy, visit the following link:
https://www.aao.org/eyenet/article/ocular-changes-during-pregnancy
References.
- ↑ 1.0 1.1 1.2 American College of Obstetrics and Gynecologists Task Force on Hypertension in Pregnancy. Hypertension in Pregnancy. Obstetrics & Gynecology. 2013;122(5):1122-1131. doi:10.1097/01.aog.0000437382.03963.88.
- ↑ 2.0 2.1 Agarwal A, Gass J. Gass' Atlas Of Macular Diseases. Edinburgh: Elsevier Saunders; 2012.
- ↑ 3.0 3.1 3.2 Ryan S, Sadda S, Hinton D, Schachat A, Wilkinson C, Wiedemann P. Retina. 6th ed. Elservier; 2018.
- ↑ 4.0 4.1 Singh K, Jain D, Wallang B. Purtscher’s retinopathy in pre-eclampsia: a blinding combination. Int Ophthalmol. 2013;34(1):103-106. doi:10.1007/s10792-013-9739-1.
- ↑ Khallouli, A.; Choura, R.; Saidane, R.; Gouider, D.; Maalej, A.; Rannen, R. Bilateral exudative retinal detachment in HELLP syndrome, first description in North Africa: A case report. PAMJ 2021, 39, 6
- ↑ Schönfeld, C.L. Bilateral Exudative Retinal Detachment in HELLP Syndrome. Case Rep. Ophthalmol. 2012, 3, 35–37.
- ↑ Teodoru, C.A., Tudor, C., Cerghedean-Florea, M., Dura, H., Tănăsescu, C., Roman, M.D., Hașegan, A., Munteanu, M., Popa, C., Vică, M.L., Matei, H.V., & Stanca, H.T. (2023). Bilateral Serous Retinal Detachment as a Complication of HELLP Syndrome. Diagnostics, 13.
- ↑ Hypertension. 2013 Nov;62(5):899-904. doi: 10.1161/HYPERTENSIONAHA.113.01890. Epub 2013 Sep 9. Changes in retinal microvascular caliber precede the clinical onset of preeclampsia. Lupton SJ1, Chiu CL, Hodgson LA, Tooher J, Ogle R, Wong TY, Hennessy A, Lind JM.
- ↑ https://www.semanticscholar.org/paper/Serial-OCT-Imaging-of-Retina-in-HELLP-Syndrome-Chen-Bhagat/39933c2a0b967a6072a3f4b799db582783c399cf